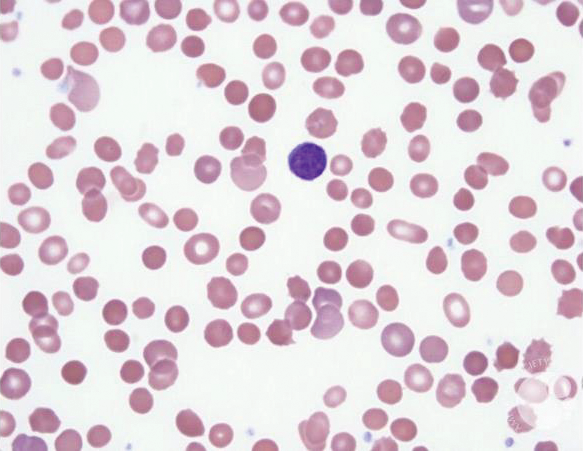
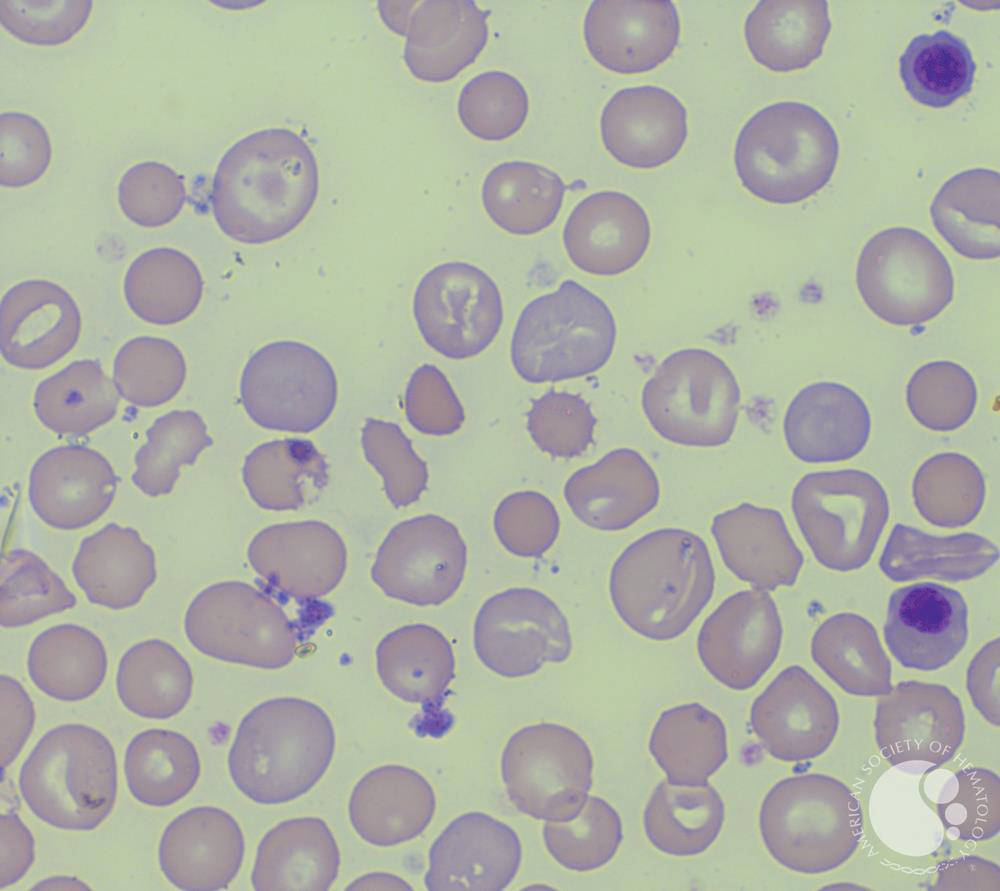

![]()
Name that inclusion
Cabot rings are thin, threadlike, red to violet rings or "figure 8" shaped inclusions in red blood cells. Cabot rings are remnants of the mitotic spindle, and can be seen in megaloblastic anemia, hemolytic anemia, medication effect, myelodysplasia and other forms of dyserythropoiesis.
What is SLIM from SLIM-CRAB?
A 50 yo F recently started a TKI for newly diagnosed CML. She presents to clinic with new shortness of breath with decreased breath sounds bilaterally to mid lungs. What drug is she likely taking?
Sprycel aka dasatinib
Pleural effusion, pericardial effusion, pulmonary hypertension, edema
Discontinue if pulmonary hypertension or recurrent pleural or pericardial effusions
The ________ criteria helps to determine if someone's history is concerning for HNPCC/Lynch Syndrome. (there's technically two...)

What is the full name of T-DM1?
Trastuzumab emtansine = Kadcyla
T-DXd = trastuzumab deruxtecan = Enhertu
Dato-DXd = datopotamab deruxtecan = Datroway
A 6-year-old boy is brought to the clinic by his parents because of a lifelong history of jaundice and episodes of fatigue. On examination, he shows mild splenomegaly. His medical history is significant for neonatal jaundice that required phototherapy. There is no known family history of hemolytic anemia. Labs c/w hemolysis. MCHC 45 g/dL, MCV 90 fL. The patient’s peripheral smear is shown below.
Which of the following tests is likely to diagnose this patient’s condition?
Eosin 5-maleimide binding test
The peripheral smear demonstrates numerous spherocytes without evidence of microspherocytes.
HS may be inherited as an X-linked dominant, autosomal dominant, or autosomal recessive condition, so the family history may not always be readily apparent.
A 66-year-old woman presents to her PCP because of hip pain. The pain worsens despite 3 months of nonsteroidal anti-inflammatory drugs and physical therapy. Magnetic resonance imaging is performed and shows a 6-cm lesion within the iliac bone. The patient has an image-guided biopsy that shows sheets of plasma cells that all stain positive for κ. sCr, Ca, Hb normal. κ light chain 14 mg/L, λ light chain 10 mg/L, SPEP w IFE = monoclonal IgG κ 300 mg/dL. UPEP neg. BMB 2% plasma cells. PET/CT wo other lesions. What is the most appropriate therapy?
Treat solitary plasmacytoma of the bone (SPB) with radiation therapy.
Rate of relapse or progression in patients with SPB = 10% over 3 years. About 40% of patients with SPB have up to 10% clonal bone marrow plasma cells = SPB with minimal bone marrow involvement. Treated like SPB, but the risk of progression is 60% over 3 years.
2/3 of patients with SPB develop MM at the 10-year follow-up, with a median time to progression of 2 years. Risk of progression to overt myeloma is higher in patients in whom a monoclonal protein persists after eradication of the plasmacytoma with local treatment.
Name (2) bispecific T-cell engaging antibody drugs targeting CD3 and CD20. Both are approved for RR DLBCL.
Epcoritamab aka EPKINLY (also approved for RR FL)
Glofitamab aka COLUMVI
Which non-inferiority trial demonstrated 3 months of CAPOX was non-inferior to 6 months of CAPOX in stage III CRC?

________ = the most common oncogenic mutation in breast cancer
PIK3CA
Mutations in 30-40% of HR+ BC
PTEN, AKT1 are much less frequent, typically 5–10% or lower
84% of all breast cancers are HR+
15–20% of all breast cancers are HER2+
A 32-year-old man with a history of congenital hemolytic anemia diagnosed in childhood presents reporting increased fatigue, pallor, and jaundice over the past month. He has been managed with periodic blood transfusions and chelation therapy for iron overload. Despite supportive care, his symptoms have recently worsened; he has not suffered from recent infections or other significant illnesses. PKLR gene testing w compound heterozygous missense mutations.
Which of the following is the most appropriate first-line treatment for this patient?
Mitapivat (small-molecule pyruvate kinase activator) is effective in approximately 50% of adults with pyruvate kinase deficiency (PKD) in raising hemoglobin, decreasing hemolysis and transfusions, and decreasing complications, including iron overload.
Name (2) high risk cytogenetic abnormalities in MM
1. Del 17pa and/or TP53 mutation
2. Bi-allelic del 1p
3. t(4;14), (14;16), or t(14;20) plus either Gain/Amp 1q or Del 1p
4. Gain/Amp 1q plus Del 1p
80 yo F w R/R AML +IDH1 presents to ED unresponsive. Cardiac monitor reveals torsades de pointes. Her family reports she just completed a course of abx for sinusitis. Which targeted therapy was the patient likely taking for her leukemia?
Either IDH1 inhibitor:
Ivosidenib (TIBSOVO) or Olutasidenib (Rezlidhia)
CYP3A4 substrate (major) & P-gp Inducer of CYP3A4, 2B6, 2C8, 2C9
Examples of strong CYP3A4 inhibitors
Antibiotics: Clarithromycin, itraconazole, and ketoconazole
Anti-HIV drugs: Ritonavir, nelfinavir, and saquinavir
Antidepressants: Nefazodone
Other medications: Verapamil and diltiazem (calcium channel blockers)
Herbal and dietary components: Grapefruit juice
Neoadjuvant treatment is standard of care in T__ Nx rectal cancers
T3
Exact sequence will likely not be tested on the boards
Fluoropyrimidine alone (capecitabine or infusional 5-FU) as radiosensitizer for long course radiation
Can avoid radiation in low-risk patients (ie not T4 or low rectal) PROSPECT
Among the FDA-approved cyclin-dependent kinase 4/6 (CDK4/6) inhibitors, ________ demonstrates the most substantial central nervous system (CNS) penetration.
abemaciclib

To date, ribo is the only CDK4/6 w SS OS.
A 50-year-old man presents to the emergency department with fatigue, dark urine, and jaundice. He was recently started on ceftriaxone for the treatment of a skin infection. On physical examination, he is pale, with scleral icterus. His blood pressure is 110/70 mm Hg, and his heart rate is 92 beats per minute. Labs consistent w drug-induced hemolysis. DAT 3+ IgG. What is the most likely mechanism of this patient’s hemolysis?
Drug-induced immune complex formation that binds to red blood cells, leading to complement activation and subsequent destruction of red blood cells.
As opposed to hapten formation (PCN), autoantibody formation, direct cell lysis by drug, etc.
A patient with newly diagnosed MM presents for C1 Dara-RVd with ultimate plan to proceed to auto transplant. What (3) antimicrobial prophylactic drugs does he need to start today?
Levofloxacin prophylaxis (500 mg PO daily) is recommended for 12 weeks after diagnosis or during neutropenia; alternatives include cefdinir or amoxicillin-clavulanate.
Antiviral prophylaxis with acyclovir or valacyclovir is indicated for patients receiving proteasome inhibitors, monoclonal antibodies, or ASCT to prevent herpes simplex and zoster reactivation.
TMP-SMX is recommended for PJP prophylaxis in high-risk patients (e.g., those on high-dose steroids or with relapsed/refractory MM).
The chimeric CD30 antibody-drug conjugate with monomethyl auristatin E (MMAE) payload utilized in cHL and CTCL has a black box warning for what?
Brentuximab vedotin
Progressive multifocal leukoencephalopathy (PML)
First Prospective Phase III of L-sided RAS WT mCRC looking at FOLFOX + bevacizumab or panitumumab which provided prospective confirmation that EGFRi is better than VEGFi for left-sided, RAS wt pts.
PARADIGM

50 yo F w metastatic HER2+ breast cancer progresses on THP with two new asymptomatic brain metastases. She has had prolonged complications from COVID w post-COVID interstitial lung disease, but otherwise remains quite fit with KPS 80%. What is your next line of therapy?
HER2CLIMB
Tucatinib + Trastuzumab + Capecitabine
T-DM1 is technically an option but less preferred w the brain mets
Update: T-dxd + Perjeta is likely to become 1st line per DESTINY-Breast-09
A 70-year-old man with a history of cold agglutinin disease (CAD) presents to the clinic with worsening fatigue, jaundice, and dark urine, especially after exposure to cold weather. He has previously been treated with rituximab, with limited benefit. Physical examination reveals pallor and cyanosis of the fingertips. Labs w hemolysis. SPEP IgM 0.5 g/dL. DAT positive for C3 only. Which therapy specifically targets classical complement activation in CAD by targeting C1s?
Sutimlimab (Cardinal study)
In clinical trials, sutimlimab has demonstrated efficacy in reducing hemolysis, improving hemoglobin levels, and decreasing the need for transfusions in CAD patients. Rituximab targets B cells and has been used in CAD, but it does not directly inhibit complement. Eculizumab inhibits complement at C5, which is effective in paroxysmal nocturnal hemoglobinuria but not CAD. Corticosteroids and plasmapheresis are not primary treatments for CAD.
A 72-year-old man with newly diagnosed multiple myeloma is started on daratumumab, lenalidomide, bortezomib, dexamethasone, and zoledronic acid. After the third cycle of therapy, he develops discomfort, redness, and swelling in the eyelid, as pictured below.

Which drug likely caused this complication?
Bortezomib is a common cause of blepharitis and chalazion. It typically presents 3 months into treatment. Most cases can be managed supportively without requiring drug discontinuation. The other medications (daratumumab, dexamethasone, lenalidomide, zoledronic acid) are not associated with this side effect.
What is the humanized IgG1k monoclonal antibody targeting C-C chemokine receptor 4 (CCR4) approved for RR mycosis fungoides and RR sezary syndrome?
Mogamulizumab aka POTELIGEO
Increased transplant complications (grade 3-4 GVHD and transplant-related death) in patients who proceed to allogeneic SCT, particularly if a shorter timeframe (~50 days) between mogamulizumab and SCT
Before treatment with EGFR antibodies, what THREE mutations do you need to rule out?
KRAS, NRAS, BRAF
BRAF is primary effector of KRAS signaling. Can impact that feedback loop w dual inhibition such as Encorafenib + Cetuximab (approved for 2nd or 3rd line mCRC with BRAF V600E)
50 yo F w metastatic HER2+ breast cancer has progressed on THP and T-dxd. She has no impending organ failure. She is found to have a low-affinity Fc receptor genotype. What treatment do you offer her next?
Margetuximab + chemo (eribulin, cape, gem, vin)
The low-affinity CD16A-158F genotype is common and predicts reduced response to trastuzumab, but margetuximab is specifically designed to enhance efficacy in these patients by improving Fc receptor binding and ADCC, increasing activation of immune effector cells.
This German pathologist, _________, was the first to use the term "leukämie" from the Greek for "white blood" in 1847 to describe patients with enlarged spleens and excessive white blood cells. He later characterized leukemia and lymphoma.
Rudolf Virchow, The Victorian “Pope Of Medicine”
